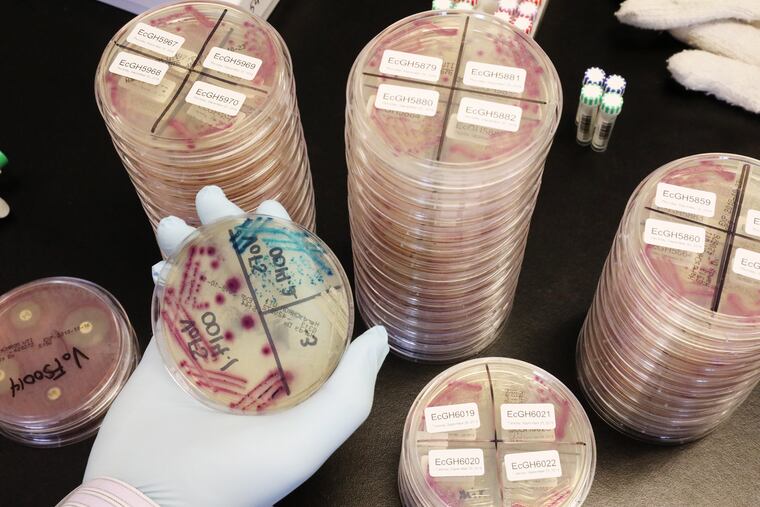

Senator Casey’s bill to fight ‘superbugs’ can help save lives | Opinion
Legislation to promote better antibiotics won’t solve the entire problem, but it’s a good first step.
One of humanity’s biggest threats is invisible to the naked eye. Drug-resistant microbes, including many common bacteria and yeasts, kill as many as 160,000 Americans each year — quadruple the number killed in car crashes. And the death toll may soon rise exponentially, because these “superbugs” are evolving faster than drug companies are developing new treatments.
Soon, drug-resistant microbial infections could kill more people than cancer. By 2050, the global body count is projected to surpass 10 million people a year.
Pennsylvania Senator Bob Casey has just introduced a bipartisan bill that could help save many patients. The DISARM Act would encourage companies to develop antibiotics and expand access to the superbug treatments patients need. The legislation won’t solve the entire problem, but it’s an encouraging first step.
Doctors use antibiotics to treat a range of bacterial and yeast infections, everything from life-threatening diseases like sepsis to routine urinary tract infections. Before antibiotics became widely available in the 1940s, the average life expectancy in the United States was 63 years. Now, it’s almost 79, largely thanks to these treatments.
Four out of five Americans are prescribed at least one antibiotic each year. The more antibiotics we take, however, the less effective they become. That’s because microbes — like all living things — adapt. When antibiotics attack an infection, some of the bacteria or yeasts occasionally survive, regrow, and cause new diseases that are resistant to the original antibiotic.
Already, the most common treatment for urinary tract infections has stopped working for half of patients. Perhaps even more disturbing, antibiotic resistance jeopardizes any medical procedure that risks infection: routine surgeries; organ transplants; chemotherapy treatments for cancer and rheumatologic or connective tissue diseases; neonatal care; and cesarean section.
Unfortunately, the development of antibiotics has slowed to a crawl. Drug companies are hesitant to pour money into new antibiotics that, by definition, should only be used for a short course of treatment and as a last resort. Patients and payers also expect antibiotics to be cheap. Firms are much more likely to pursue cancer or cardiovascular drugs, which command high prices and must be taken for longer periods of time.
It’s not surprising, then, that more than 30 years have passed since the last truly novel class of antibiotics was discovered.
A number of small biotech firms are investigating new treatments, but they’re struggling to survive. Six in 10 companies with antibiotics in any stage of development worldwide are “pre-revenue,” meaning they don’t have any products on the market. Recently, a company with a newly approved antibiotic against one of the toughest superbugs filed for bankruptcy just nine months after receiving FDA approval.
Casey’s proposal, the “Developing an Innovative Strategy for Antimicrobial Resistant Microorganisms,” works primarily by adjusting how Medicare pays for certain antibiotics.
Currently, Medicare doesn’t reimburse hospitals for the full value of new antibiotics. Hospitals don’t want to lose money, so patients who need antibiotics generally receive older, cheaper ones. In many cases, older antibiotics are adequate. Sometimes, however, more innovative antibiotics are required but not prescribed. For example, a new antibiotic that fights one particularly stubborn superbug is used only half as often as it should be, according to a paper my colleagues and I will soon release.
The DISARM Act would enable Medicare to provide additional funding to hospitals when advanced antibiotics are used, so long as those medicines are appropriately deployed. This will help make sure patients get the right drugs at the right time and encourage companies to develop new treatments.
DISARM would also require hospitals to establish antibiotic “stewardship” programs to optimize patient outcomes, reduce inappropriate use of treatments, and better track how and why antibiotics are utilized.
The bill has bipartisan support — Casey’s Republican colleague, Sen. Johnny Isakson of Georgia, is a cosponsor. But the DISARM Act can’t stand alone.
Legislators should also create market entry rewards for newly approved antibiotics. Such rewards would ensure a sustainable economic return for vital antibiotic research and development, even if new drugs mostly stay on the shelf until they’re needed. Investing in market initiatives won’t just save lives, it’s also financially savvy. Antimicrobial resistance already costs our nation $20 billion a year.
Drug-resistant superbugs will kill tens of millions of people by causing infections and by jeopardizing lifesaving medical advancements. It’s time to develop new antibiotics and more appropriately use today’s treatments.
Cornelius J. Clancy, MD is the VA Pittsburgh Healthcare System’s chief of infectious diseases, and an associate professor of medicine and director of the XDR Pathogen Lab at the University of Pittsburgh.